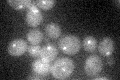
YJR135C
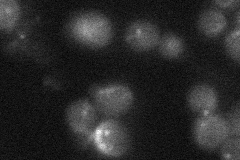
YJR135C
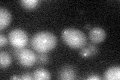
YJR135C
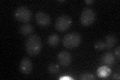
YJR135C

View description
Protein involved in minichromosome maintenance; component of the kinetochore; binds to centromeric DNA in a Ctf19p-dependent manner
Localization:
Intensity:
Fold change:
Significance:
-
C’ GFP library in SD
punctate21.42 -
N' NOP1pr-GFP in SD

cytosol,punctate46.205 -
N' TEF2pr-mCherry in SD

punctate37.5972 -
N' NATIVEpr-GFP in SD
punctate20.028 -
N' TEF2pr-VC and Cyto-VN in SD

below threshold27.3663 -
C’ GFP library in SD+DTT
punctate22.61.05No -
C’ GFP library in SD+H2O2

punctate18.450.86No -
C’ GFP library in Starvation Media
punctate26.481.23No -
C’ GFP library on the background of Pup2-DaMP

punctate -
C’ GFP library on the background of CCT mutant

punctate19.84270.926111No
